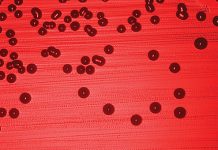
CZY KLIENT MOŻE MNIE ZARAZIĆ?

Skuteczna ochrona przed grzybicą stóp Co warto wiedzieć?
Grzybica jest powszechną i wieloczynnikową chorobą, która może pojawić się w każdym wieku, zarówno wśród osób zdrowych, jak i chorych z obniżoną odpornością. Grzybice można podzielić...
CZY KLIENT MOŻE MNIE ZARAZIĆ?
Zawód kosmetyczki jest zawodem podwyższonego ryzyka wynikającego z niebezpieczeństwa zakażenia chorobą na skutek kontaktu z chorym klientem. Uważa się, że salon kosmetyczny należy traktować jak gabinet...
Związki siarki w kosmetyce
Streszczenie
Jednym z wielu pierwiastków niezbędnych do prawidłowego funkcjonowania organizmu ludzkiego jest siarka. Jej niedobór wywołuje choroby skóry, włosów i paznokci, dlatego ważne jest stosowanie związków tego pierwiastka w preparatach...
Srebro i kosmetyki
Streszczenie
Srebro, często nazywane „naturalnym antybiotykiem”, posiada silne właściwości przeciwbakteryjne. Jest używane w medycynie i biologii od wielu lat, obecnie przeżywa swój renesans. Wynika to z dynamicznie rozwijającej się nauki...
Analiza właściwości miodu pszczelego i jego zastosowanie w dietetyce i kosmetologii
Streszczenie
Prawidłowe funkcjonowanie organizmu wymaga odpowiedniej ilości substancji odżywczych, do których należą m.in. związki antyoksydacyjne, w tym miód, który jest naturalnym przeciwutleniaczem. Lecznicze i smakowe walory miodu poznano już w...
Wpływ elektrostymulacji na zmiany obwodu ud i talii oraz wskaźnika masy ciała u kobiet
Streszczenie
Elektrostymulacja jest zabiegiem elektroleczniczym wykorzystującym prądy impulsowe niskiej i średniej częstotliwości, coraz częściej stosowanym w salonach odnowy biologicznej. W pracy przedstawiono wpływ serii zabiegów elektrostymulacji mięśni brzucha oraz ud na...